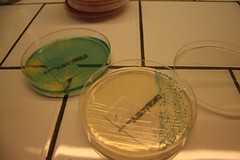

フリーのアクセス解析ツールがまとめて紹介されていたので目的別に書き留めておきます。
わかりやすさを求める人におすすめ(無料なのは1日1000PVまで)

インターフェースがわかりやすいのが特徴のClicky、Performancing Metricsというサービスがそのまま名前を変えているようですが、(前向きストラテジー、著者の方の情報)個人的にSPY機能が気に入ってます。
Clickyのスクリーンショット
PPC広告を解析したい人におすすめ
Enquisiteは、検索エンジン及びPPCからのトラフィックに大して焦点を合わせられるようです。 ページと地域のデータを、ページポジションを含む詳細な統計値を確認できるみたいです。スクリーンショットからもその詳細さが見て取れますね。
Enquisiteのスクリーンショット
サイト内での訪問者の動きを視覚的に解析したい人におすすめ
CrazyEgg、このサービスは試した方も多いのではないでしょうか、特徴はサイト訪問者がどこをクリックしているかをヒートマップで視覚的に教えてくれるところですね。
CrazyEggのスクリーンショット
今は予約のみ受付
Measure MapGoogleが買収したアクセス解析ツール。現在はアカウントを発行していませんが、予約!?をできるようになっているようです。スクリーンショットを見る限りでは、訪問者の地域を解析することに特化しているようです。
Measure Mapのスクリーンショット
アクセスカウンター機能も求める方におすすめ
graphs.amung.usは、リアルタイムの訪問者カウンター。たまに設置しているブログを見ますね。
今何人見てる?カウンター↓、実際にこのページのグラフをご覧いただけます。
whos.amung.usのスクリーンショット
RSSフィードを解析したい人におすすめ
FeedBurner、こちらもGoogleによって買収されたRSSフィードを利用したアクセス解析ツール。RSSフィードの購読者の数値はあまり正確ではないと言われていますが、解析できないよりはできたほうがいいですよね。
ちなみにGoogleによる買収の甲斐あって、Google Analyticsにサイトへの誘導数を分かりやすく表示させる機能も付与されました。とはいっても、URL 生成ツールで生成されるようなパラメータを付与されるということなのですがね。。。日本語が文字化けするけれど、分かりやすいのはGoodです。
↑Google Analyticsに表示されるFeedburnerからの流入データ。
リアルタイムに訪問者の動きを見たい方におすすめ
SnoopはClickyのSPY機能をさらに強化させたとも言うべき、リアルタイムな訪問者のトラッキングを計れるツールです。IPアドレスに名前をつけることもできるとか、本格的に解析していけば、どんな人がどんな頻度で訪問してくるかとかを計れそう。
Snoopのスクリーンショット
サイト内での訪問者の動きを超視覚的に解析したい人におすすめ
ClickTaleは文字通り訪問者の行動を記録し、動画で行動の奇跡を見れるようになっています。
以前にもこのようなサービスはありましたが、さらに機能が強化されているようですね。
ClickTaleのスクリーンショット
こうやって並べてみると、それぞれに特徴があっておもしろいですね。大企業でない限り、有料のアクセス解析ツールにすべての機能を求めるよりも、目的に合わせて無料の解析ツールを使ったほうが深く解析することができそうです。

リアルタイムにデータが見れるというのはポイントが高いですよね。